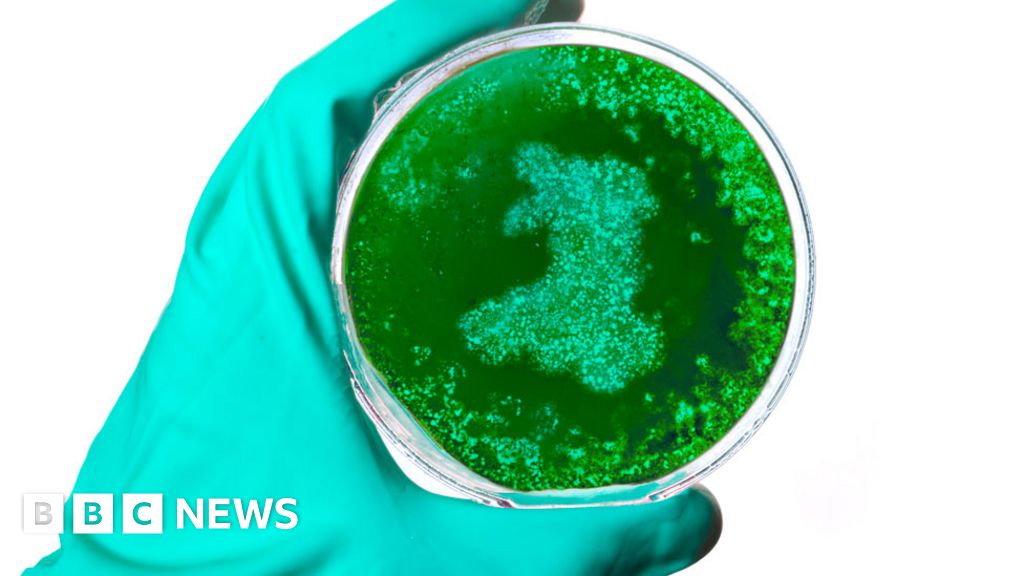

What could Brexit mean for the NHS in Wales?
[ad_1]
BBC Wales health correspondent
 Thinkstock
ThinkstockWhat could be the impact of Brexit on the NHS in Wales? Here are some of the potential issues.
The majority view among economists is that leaving the EU will damage the economy – the severity of the impact will depend on what form of Brexit will take. But why should this matter to the NHS in Wales?
With health and social care accounting for nearly half the Welsh Government’s budget, its spending decisions and, ultimately, how much money it receives from Westminster are significant.
But Mr Fahy said there is less room for budgetary manoeuvre for devolved governments like Wales over their spending and there was a “real risk” if there was economic pressure on the UK it would have an impact on the health service.
He said it could mean a “substantial increase in delays”, particularly people waiting for preventive, ongoing care and elective surgery.

Staff from EU countries play an important role in sustaining health and care services. Across the UK it is estimated 60,000 people from other EU countries work in the NHS and 90,000 work in adult social care.
In Wales, about 30% of our 8,800 doctors are trained abroad. But only 18.5% of these foreign-trained doctors come from the European Union.
Across the NHS in Wales, just over 2% of all staff are from the EU – but this compares to around 10% of the NHS workforce in London and 5% in England as a whole.
It can be argued then that Wales will face less of an impact in the short term from any loss of EU workers.
But it might not be as simple as that.
Nick Fahy fears a potential brain drain from Wales to areas like London and the south east, if hospitals there lose EU staff. He said training UK-born staff would take time and money.
Carol Shillabeer, chief executive of Powys health board, said: “I think uncertainty is huge and reducing it is an important priority.
“We don’t know if people have moved already but I’m sure some EU members of our workforce have thought about it, despite the best efforts in the NHS to let them know we value them highly.”
But Andrew Furber, president of the Association of Directors of Public Health, said: “For Wales, there’s an opportunity here to attract in a workforce from across the UK, give them the quality of life and [lower] cost of living, there’s potentially an opportunity to strengthen that workforce not only by growing your own but attracting them in.”

PUBLIC HEALTH MEDICINES AND RESEARCH
 Getty Images
Getty ImagesThe UK and the EU collaborate in many aspects of health and care. EU law governs nearly every aspect of the process of licensing new medicines – which are often trialled across borders.
A huge amount of work also occurs on a European level on public health to improve air quality, for example.
British researchers and institutions also benefit from access to EU networks and infrastructure. It is estimated that 16% of the academic workforce in the UK comes from the EU. So what happens next?
“The risk to us in the medium and long term is we simply will not get access – we won’t be part of the clinical trials to give patients drugs at that early and developmental stage and won’t be a priority destination for companies once they start to market their drugs around the world,” said Mr Fahy.
Powys health board worked with 16 regions in Europe – not all EU members – and was given €500,000 (£445,000) to invest in and test new ways of providing mental health services through the internet.
“I’m optimistic in some ways,” said Ms Shillabeer. “As health professionals and academics we will continue to work beyond whatever the deal is with Brexit.
“Often there is an international community of expertise and sharing but can we access that funding?”

About one in every five people live in poverty in Wales and levels have proved stubbornly difficult to reduce.
Add to that the estimate that health inequalities are costing the country £3-4bn each year through illness, lost productivity and taxes, and higher welfare payments.
Wales has been classed as one of Europe’s poorest areas for nearly two decades and benefited from EU funds specifically aimed at reducing the gap between rich and poor.
There are arguments about how well that £4bn was spent but what will happen in the future?
Steve Thomas, chief executive of the Welsh Local Government Association (WLGA), argues that Wales could well have qualified for yet another round of EU funding if Britain had remained.
“There are structural problems in the Welsh economy which will take years and years to work out of the system, not least of all the demise of traditional industries and the health impacts of that.
“We want to see something like that [EU funding] going forward in terms of a new regional policy.”
Public health experts said developing community “anchors” relevant to modern day life could also help mitigate those inequalities.
Mr Furber said: “Part of the reason behind the Brexit vote in the first place is people felt society wasn’t treating them as fairly as it ought to and it was a pretty unequal society they are living in now.
“If that is not addressed as part of the exit from the EU we will have a lot of people who are disappointed.”

Those who have championed the case for Brexit have been clear – leaving the EU is not a threat but an opportunity.
It is an opportunity to reinvest the cash that was sent to Brussels back into public services here.
It is also an opportunity to tailor bespoke policies for the UK’s needs in a system freed from the shackles of EU rules, regulations and red tape.
Forget the doom and gloom they argue – leaving the EU can be a new dawn.
Ms Shillabeer said it could give more impetus to changes in health and social care in how services are delivered and how the workforce develops in future.
“There’s a real opportunity for Wales to step up and work more collaboratively around what the future workforce could look like,” she said.
“The sense of having health and social care workforce planning together, having qualifications and support that can bring people in at social care level right through to registered professionals. There’s an onus on us in Wales to up our offer and game here.”
Procurement – the set of rules for public services to buy their goods and services – is another area which could provide more flexibility post-EU and help grow Welsh business in working with the NHS.
“I thought possibly one of the beneficial things to come from Brexit was an end to state aid and the Brussels procurement regime which has been a pain,” said Mr Thomas, boss of the WLGA.
“But if we want to sell into that European market and deal with it in terms of purchasing goods and services then we still have to use that regime.”
Mr Fahy said there could be no more excuses once Britain had left the EU for getting the health service right.
“We’re going to be confronted with challenges to our NHS, challenges to our society, deep-rooted inequalities and economic pressures we’ve not encountered in generations. It will only be up to us how we address them. That’s the real challenge of Brexit.”
- Mr Fahy is one of several health experts who have been sharing their views about the potential impact of Brexit on health in Wales in advance of Public Health Wales’ annual conference, which begins on Thursday.
[ad_2]
Source link





